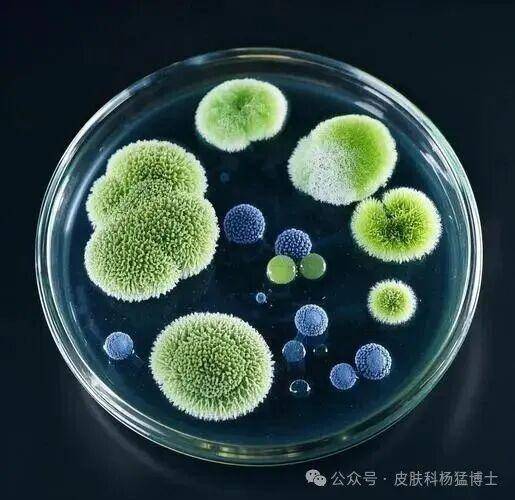

在医学领域,梅毒被称为"伟大的模仿者"。这种古老的疾病如同一名狡猾的演员,能够伪装成数十种其他疾病的模样,从皮肤问题到神经系统异常,甚至模仿心血管疾病的表现。它的千变万化让无数医生在诊断时陷入困惑,也让患者因误诊而延误治疗。今天,我们就来揭开这位"模仿大师"的真实面目。

隐秘的入侵者:梅毒螺旋体的传播途径

梅毒螺旋体这个微小的病原体,主要通过三种方式悄无声息地侵入人体。性接触传播是最主要的途径,无论是异性还是同性之间的亲密行为,都可能成为传播的温床。想象一下,这种螺旋形的微生物就像一把微小的钻头,通过皮肤黏膜上细微到肉眼看不见的破损处,轻松钻入新的宿主体内。

母婴传播则更为残酷,感染的孕妇会将病原体通过胎盘传递给胎儿,或在分娩过程中直接传染给新生儿。这就像在生命最初的旅程中,就背负上了不该承受的重担。虽然血液传播在当今医疗条件下已大幅减少,但共用针具等行为仍可能带来风险。值得注意的是,偶尔也有通过共用毛巾、剃须刀等日常用品传播的案例,虽然罕见却提醒我们保持个人卫生的重要性。

千面梅毒:不同阶段的"表演艺术"
梅毒的病程发展就像一场精心编排的三幕剧,每一幕都有其独特的"表演风格"。

第一幕:一期梅毒通常在感染后2-4周拉开帷幕,表现为硬下疳——一个无痛性溃疡,常出现在生殖器部位。这个看似无害的小伤口实则暗藏杀机,就像敌人在城门外挖的地道,为后续大军入侵做准备。伴随而来的还有硬化性淋巴结炎,淋巴结变得像橡皮一样坚硬。

第二幕:如果一期梅毒未经治疗,6-8周后将进入更为张扬的二期。这时梅毒螺旋体已经通过血液播散全身,演员开始更换各种"服装"亮相——可能是玫瑰色的梅毒疹,也可能是潮湿部位的扁平湿疣,或是令人担忧的梅毒性脱发。这些皮疹就像身体发出的求救信号,可惜常常被误认为是普通皮肤病。

第三幕:经过数年甚至十数年的潜伏,约三分之一未治疗的患者将迎来最危险的终章——三期梅毒。这时病原体已经深入内脏,可能攻击心血管系统形成主动脉瘤,就像在血管里埋下定时炸弹;也可能侵蚀神经系统,导致瘫痪、痴呆等严重后果;还可能在皮肤、骨骼等部位形成树胶肿——一种破坏性极强的炎性肿块。

诊断的迷宫:如何识破"模仿者"的真面目
梅毒的诊断就像在玩一场高难度的"大家来找茬"游戏。由于症状多变且常与其他疾病相似,实验室检查成为关键武器。血清学检测是最常用的方法,通过检测血液中针对梅毒螺旋体的抗体来确诊。这就像在茫茫人海中通过DNA比对找出真凶。

早期诊断尤为重要,一期和二期梅毒的治疗效果最佳。医生可能会结合病史、体检和多种实验室检查来拼凑真相。值得注意的是,梅毒还可能与其他性传播疾病如HIV共同感染,使得诊断更加复杂。这就像犯罪团伙协同作案,需要更全面的侦查手段。
对抗模仿者:现代医学的武器库
面对这个狡猾的对手,现代医学已经建立起相对完善的治疗体系。青霉素类药物仍是首选武器,能有效杀灭梅毒螺旋体。对于青霉素过敏的患者,四环素、红霉素等抗生素可作为替代选择。


治疗过程需要根据疾病阶段制定策略:早期梅毒可能只需一次青霉素肌肉注射,而晚期或神经梅毒则需要大剂量静脉用药。这就像对付不同规模的敌军,需要调整兵力部署。物理治疗如激光和冷冻可作为辅助手段,针对局部病灶进行精准打击。

漫长的战役:治疗后的持久战
战胜梅毒不是一蹴而就的事情,更像是一场需要耐心的持久战。治疗后第一年需要每三个月复查血清学指标,第二年改为半年一次,直到第三年末完成最后一次复查。这就像战争结束后的维和任务,确保没有残敌死灰复燃。

心理支持在这场战役中同样重要。患者往往承受着巨大的心理压力,需要家人朋友的理解与支持。同时,预防传播的措施必不可少——治疗期间避免性行为,个人物品单独使用并消毒,性伴侣也应接受检查。


预防优于治疗:构筑防线的智慧
面对这个"伟大的模仿者",预防永远是最明智的选择。安全性行为是第一条防线,正确使用安全套能大幅降低感染风险。这就像在城门处设置严密的安检系统。
对于计划怀孕的女性,孕前检查应包括梅毒筛查,避免悲剧传递给下一代。保持良好的个人卫生习惯,不与他人共用可能接触血液的物品,都是简单有效的防护措施。

梅毒这个古老的疾病至今仍在全球范围内影响着数百万人。了解它的真面目,识破它的伪装,才能在这场持续了几个世纪的战争中占据上风。记住,早期诊断和规范治疗是关键,而预防永远是最好的"疫苗"。在这个信息爆炸的时代,让我们用知识武装自己,不再被这个"伟大的模仿者"所迷惑。积极践行安全性行为,正确使用防护用具,定期进行健康筛查。医疗机构也应加强科普宣传与精准检测技术应用,共同织密防控网络,阻断传播链条,守护公众健康防线。

